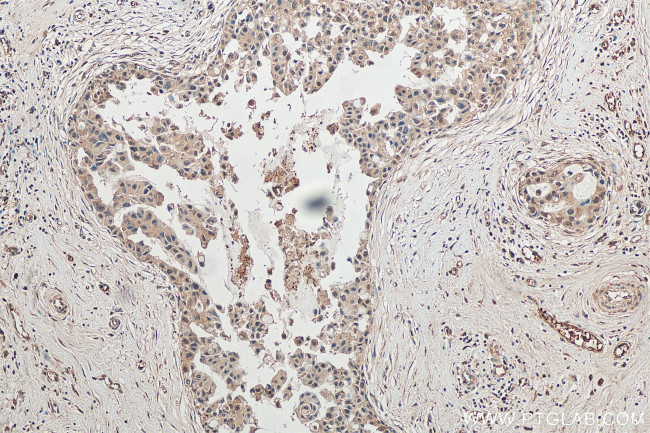
ITCH Antibody in Immunohistochemistry (Paraffin) (IHC (P))

Search
Proteintech
ITCH Polyclonal Antibody
{{$productOrderCtrl.translations['antibody.pdp.commerceCard.promotion.promotions']}}
{{$productOrderCtrl.translations['antibody.pdp.commerceCard.promotion.viewpromo']}}
{{$productOrderCtrl.translations['antibody.pdp.commerceCard.promotion.promocode']}}: {{promo.promoCode}} {{promo.promoTitle}} {{promo.promoDescription}}. {{$productOrderCtrl.translations['antibody.pdp.commerceCard.promotion.learnmore']}}
产品信息
20920-1-AP
种属反应
宿主/亚型
分类
类型
抗原
偶联物
形式
浓度
规格
纯化类型
保存液
内含物
保存条件
运输条件
产品详细信息
Immunogen sequence: TLFEDSFQQ IMSFSPQDLR RRLWVIFPGE EGLDYGGVAR EWFFLLSHEV LNPMYCLFEY AGKDNYCLQI NPASYINPDH LKYFRFIGRF IAMALFHGKF IDTGFSLPFY KRILNKPVGL KDLESIDPEF YNSLIWVKEN NIEECDLEMY FSVDKEILGE IKSHDLKPNG GNILVTEENK EEYIRMVAEW RLSRGVEEQT QAFFEGFNEI LPQQYLQYFD AKELEVLLCG MQEIDLNDWQ RHAIYRHYAR TSKQIMWFWQ FVKEIDNEKR MRLLQFVTGT CRLPVGGFAD LMGSNGPQKF CIEKVGKENW LPRSHTCFNR LDLPPYKSYE QLKEKLLFAI EETEGFGQE (556-903 aa encoded by BC011571)
靶标信息
Atrophin-1 contains a polyglutamine repeat, expansion of which is responsible for dentatorubral and pallidoluysian atrophy. The protein encoded by this gene interacts with atrophin-1. This encoded protein is a closely related member of the NEDD4-like protein family. This family of proteins are E3 ubiquitin-ligase molecules and regulate key trafficking decisions, including targeting of proteins to proteosomes or lysosomes. This encoded protein contains four tandem WW domains and a HECT domain. It can act as a transcriptional corepressor of p45/NFE2 and may participate in the regulation of immune responses by modifying Notch-mediated signaling. It is highly similar to the mouse Itch protein, which has been implicated in the regulation and differentiation of erythroid and lymphoid cells.
仅用于科研。不用于诊断过程。未经明确授权不得转售。
生物信息学
蛋白别名: AIP4; atrophin-1 interacting protein 4; Atrophin-1-interacting protein 4; dJ468O1.1; E3 ubiquitin-protein ligase Itchy; E3 ubiquitin-protein ligase Itchy homolog; HECT-type E3 ubiquitin transferase Itchy homolog; Itch; itchy E3 ubiquitin protein ligase homolog; NAPP1; Nedd 4 like ubiquitin protein ligase; NFE2-associated polypeptide 1; unnamed protein product
基因别名: 6720481N21Rik; 8030492O04Rik; A130065M08; ADMFD; AIF4; AIP4; C230047C07Rik; ITCH; NAPP1
UniProt ID: (Human) Q96J02, (Mouse) Q8C863
Entrez Gene ID: (Human) 83737, (Mouse) 16396